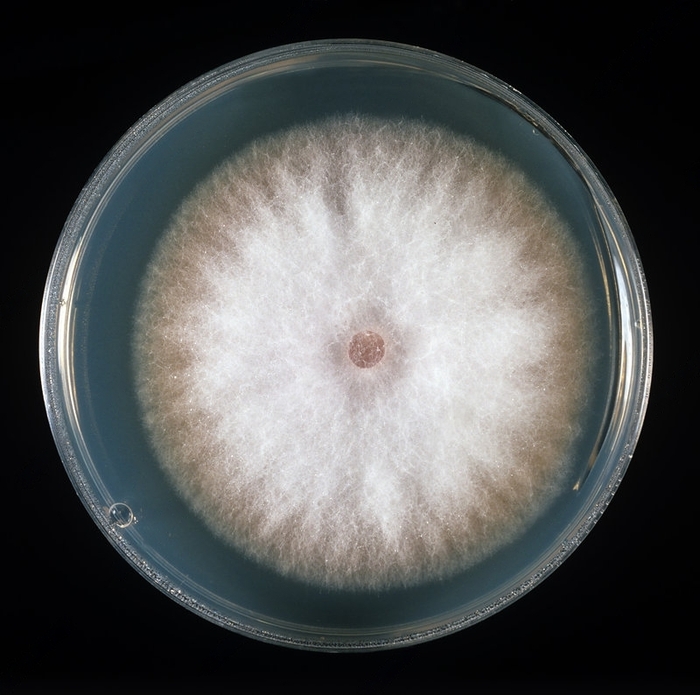

Панамская болезнь бананов под микроскопом
Микрофотография грибка Fusarium oxysporum (синий цвет) в тканях листьев банана (Musa sp.).
Этот грибок вызывает панамскую болезнь бананов. Нити грибка (гифы) прорастают внутри растения, используя питательные вещества клеток, что приводит к увяданию и гибели.
При этом на поверхности листьев образуются спороносящие структуры из-за чего всего от одного зараженного растения патоген может чрезвычайно быстро распространится по всей плантации.
Нити гриба внутри клеток листа. Увеличение х750. Сканирующий электронный микроскоп. "Камешки" внутри клеток - это зёрна крахмала.
В настоящее время не существует эффективных средств для борьбы с этим грибком, он устойчив к действию химикатов и фунгицидов. При обнаружении патогена все заражённые и близлежащие к ним растения сжигаются.
Пораженное грибком растение
Бонус: Грибок на питательной среде в Чашке Петри

Лига биологов
11K постов18.6K подписчиков
Правила сообщества
‣ Правила сайта никем не отменялись.
‣ Будьте вежливы и сдержаны.
‣ Не разводите политоту, не тащите спам.
‣ Пост-определялка. Если хотите определить представителя флоры или фауны, можете спросить там, я обязательно постараюсь помочь.
‣ Выносятся посты содержащие антинаучные и другие сомнительные идеи. Их авторы караются на месте.
‣ Так как в сообществе отключена премодерация, могут проходить посты по тем или иным причинам не подходящие под формат сообщества. Такие посты переносятся в общую ленту.
‣ Администратор иногда переносит в сообщество посты подходящей тематики, которые ей особенно понравились, не серчайте, считайте комплиментом.
‣ Если в пост закралась грубая ошибка, не удивляйтесь, если администратор попросит её исправить.
‣ Вбросы антинаучных идей и попросту различная глупость в комментариях расцениваются как развлечение для публики. Такие сообщения отдаются на растерзание толпе, как и их авторы, будь то тролли, адепты всех мастей или просто недальновидные личности.
‣ Политика сообщества не предусматривает раздачу банов направо и налево, однако, если вы нарушаете покой пользователей, и на вас пожаловались – не обижайтесь.